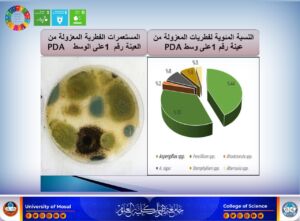

31 أغسطس، 2025
رسالة ماجستير في كلية العلوم تبحث في كفاءة الفطريات لإزالة المعادن الثقيلة من التربة الملوثة بالديزل

ناقش قسم علوم الحياة في كلية العلوم بجامعة الموصل، يوم الأحد الموافق 31 آب 2025، رسالة الماجستير الموسومة ” تقييم كفاءة بعض الفطريات المعزولة من التربة الملوثة بوقود الديزل في إزالة بعض المعادن الثقيلة ” ، التي تقدم بها الطالب فيصل قاسم حجي من فرع علم النبات.
وحضر جانباً من المناقشة السيدة عميد كلية العلوم الأستاذ الدكتورة هيام عادل إبراهيم، إضافة إلى السيد رئيس القسم وعدد من تدريسي الكلية.
ركزت الرسالة على تشخيص الفطريات المظهرية والمجهرية والجزيئية المعزولة من التربة الملوثة بوقود الديزل في مناطق مختلفة من محافظة نينوى، حيث أظهرت النتائج أن جميع العينات المدروسة غنية بالتنوع الميكروبي من الفطريات (أعفان وخمائر). كما تم تسجيل سبع عزلات فطرية في المركز الوطني لمعلومات التقانات الحيوية (NCBI).
وبيّنت نتائج الفحوص الطيفية أن عينات التربة تحتوي على تراكيز متفاوتة من المعادن الثقيلة، شملت: الزنك، الرصاص، الكادميوم، والبوتاسيوم. وشملت الدراسة تقييم قدرة أنواع مختارة من الفطريات مثل Aspergillus flavus، وFusarium chlamydosporum، وAlternaria botrytis، وغيرها، في النمو ومقاومة تراكيز محددة من هذه المعادن من خلال:
- اختبار مؤشر التحمل.
- قياس التراكم الحيوي للعناصر الثقيلة داخل خلايا الفطر.
- تقدير الامتصاص الذري للمعادن في الأوساط الزرعية السائلة.
- التحليل بالمجهر الإلكتروني الماسح (SEM).
وهدفت الدراسة إلى:
- اختبار المحتوى الميكروبي للتربة الملوثة بالديزل.
- التشخيص المظهري والمجهري والجزيئي للفطريات المعزولة.
- تقييم كفاءة الفطريات في إزالة بعض العناصر الثقيلة من البيئة الملوثة.
وقد ترأست لجنة المناقشة الأستاذ المساعد الدكتورة فاتن نوري ملا عبد، وعضوية كل من الأستاذ المساعد الدكتور عبد المنعم محمد، والمدرس الدكتور زكريا سامي عبدالرزاق، وبإشراف وعضوية الأستاذ الدكتورة هديل أحمد العامري.
ينسجم هذا البحث مع أهداف التنمية المستدامة، وبشكل خاص:
- الهدف الثالث: الصحة الجيدة والرفاه، عبر الحد من أخطار التلوث على الإنسان.
- الهدف السادس: المياه النظيفة والنظافة الصحية، من خلال معالجة الملوثات البيئية.
- الهدف الخامس عشر: الحياة في البر، لما له من دور في حماية التربة والتنوع الأحيائي.
تمنياتنا لطلبتنا الأعزاء دوام الموفقية والنجاح.
شعبة الاعلام والاتصال الحكومي
الاحد 31 آب 2025